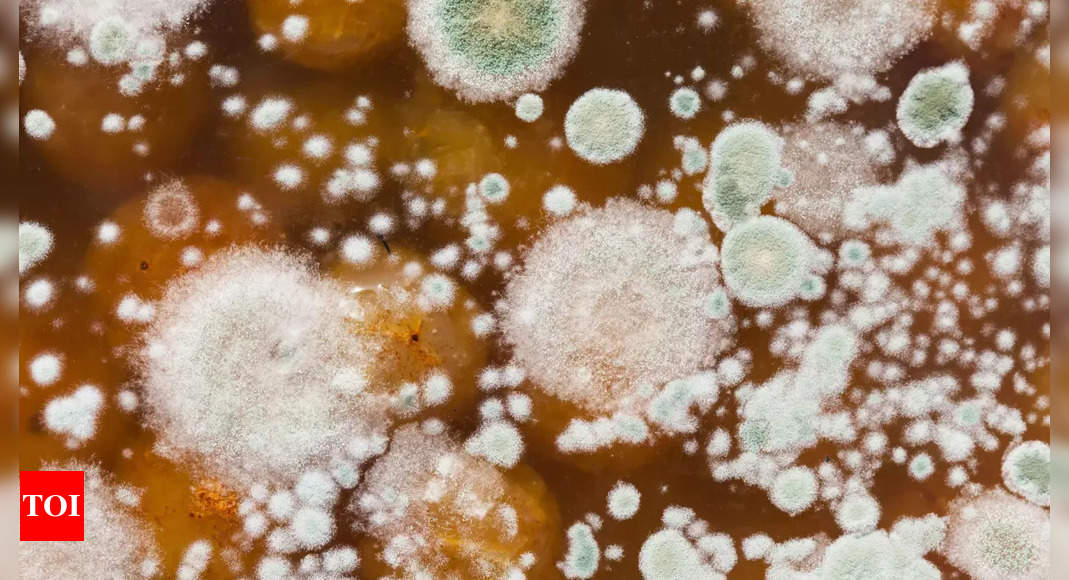

Unprecedented Case: Human Infected by Plant Fungus
In what is believed to be the first reported case of its kind, a 61-year-old mycologist in India contracted a serious case of silver leaf disease caused by the fungus Chondrostereum purpureum. The infection, which typically affects plants, manifested in the man's throat, causing symptoms such as coughing, hoarse voice, and difficulty swallowing. The case highlights the potential for pathogens to cross kingdoms and infect humans, and the challenges in developing vaccines and therapies for fungal infections. The patient's infection was successfully treated with antifungal medication, and he remained infection-free after two years of follow-up.